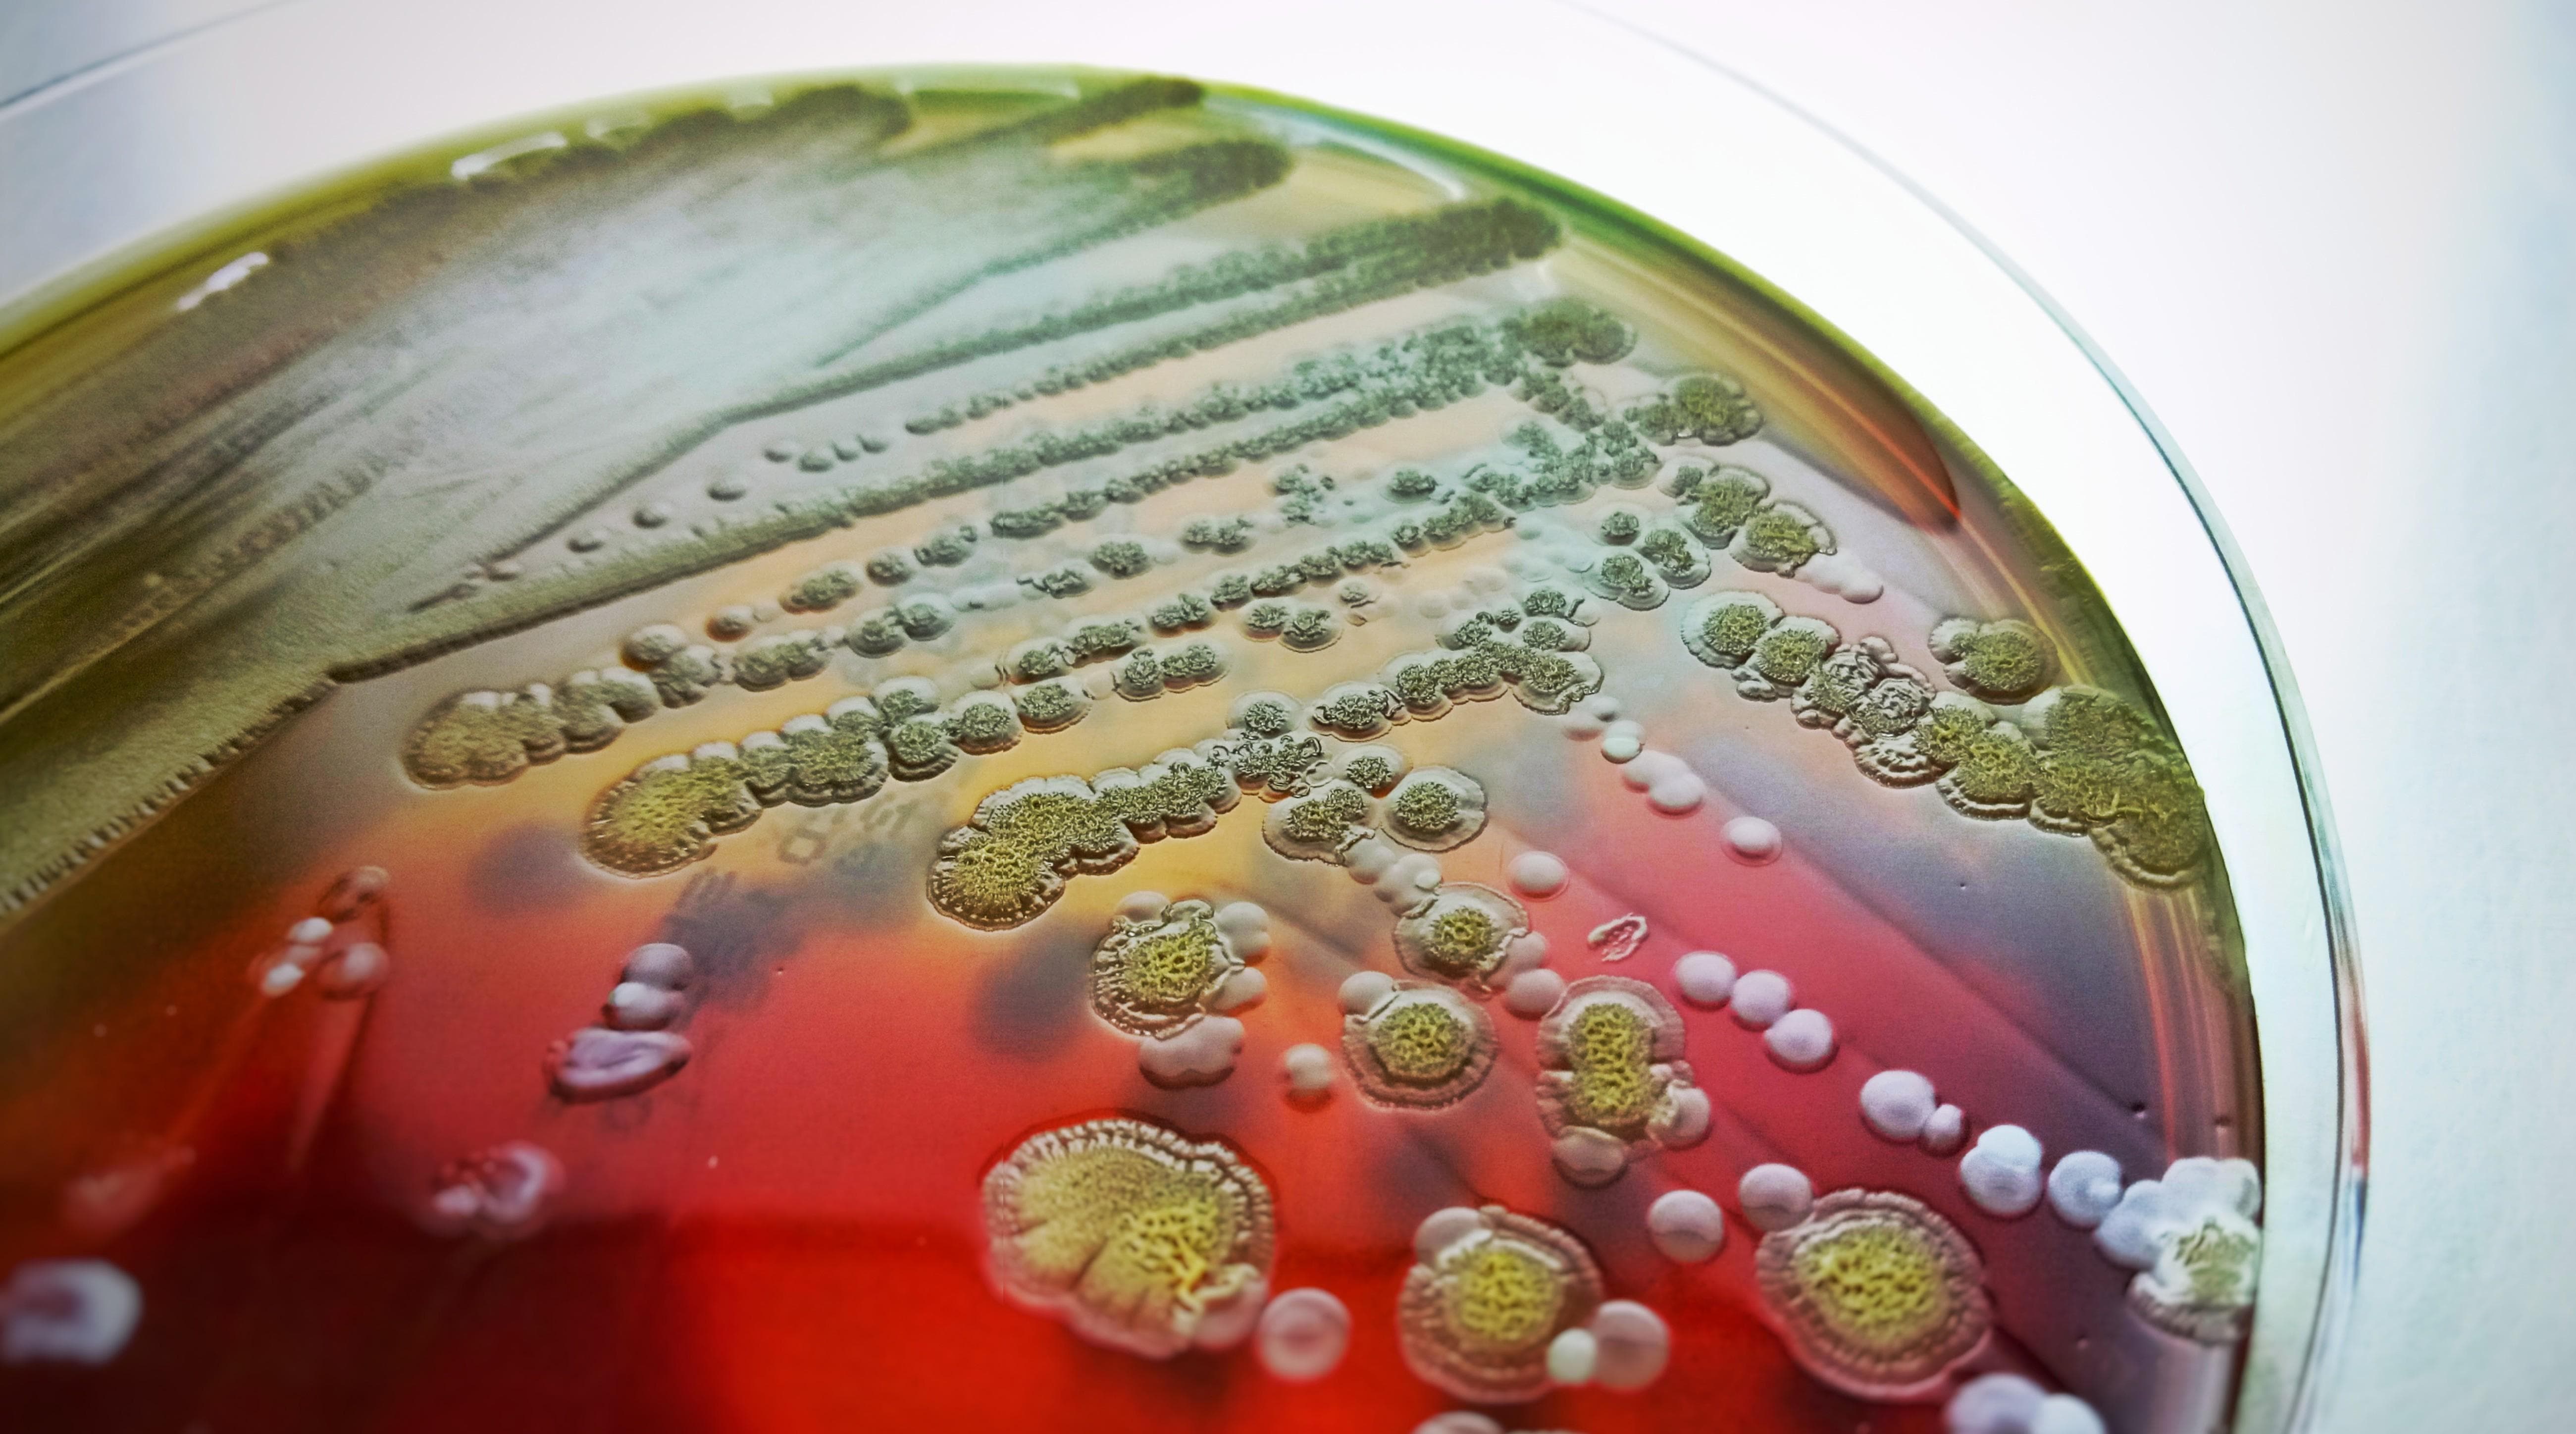
article-item

In depth articles on infectious diseases, infectious disease research, solutions and treatments

Pharmafile speaks to DeepDrug: DeepDrug tells Pharmafile about the development of new drugs for neglected and infectious diseases, including how AI can be used in the drug development process
Following a global survey on antimicrobial resistance, a global plan has been initiated by WHO, this article explores the further steps that can be taken in AMR planning

Health data systems can be used to directly help patients engage with their care and build trust with their HCPs, this article explores these strategies, placing patient outcomes at the centre of care

AI can help infectious diseases remain in the spotlight and help them gain interest from R&D investors, this article explains how